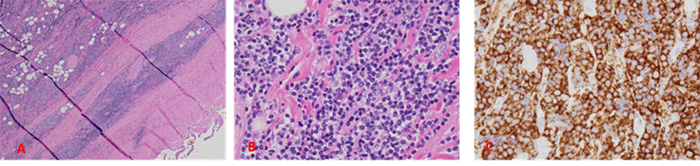
A (H&E stain, 40x): Transmural infiltration of atypical lymphocytes with mixed morphology (small, intermediate, large size) and round to irregular nuclei with condensed chromatin. B (H&E stain, 400x): Higher magnification view of atypical lymphocytes. C (CD20 immunostain): Positive staining for CD20 highlights B-cell lineage of the atypical lymphocytes
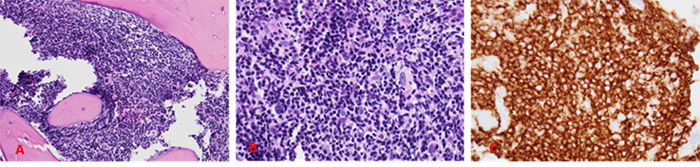
A and B): Hypercellular marrow (90%) with increased infiltration of atypical lymphocytes (predominantly small with scattered intermediate and large cells) is seen on H&E staining (40x and 400x magnification, respectively). C): Immunostaining for CD20 highlights the atypical B cells

Abstract
Background
Gallbladder lymphomas, both primary and secondary non-Hodgkin lymphoma (NHL), are exceptionally rare, constituting only an estimated 0.1% to 0.2% of all gallbladder malignancies. The vast majority (approximately 98%) of gallbladder malignancies are adenocarcinomas. Due to the scarcity of gallbladder lymphomas, they are typically documented in case reports. This case presentation describes a patient with low-grade NHL involving the gallbladder diagnosed at our high-volume academic institution.
Summary
A 65-year-old man with a one-year history of biliary colic underwent laparoscopic cholecystectomy for cholelithiasis. Pathology revealed chronic cholecystitis and a focal transmural atypical lymphoid aggregate. Further workup with immunohistochemistry, molecular studies, and imaging studies established the diagnosis of a low-grade mature B-cell lymphoma involving the gallbladder.
Conclusion
Gallbladder involvement by non-Hodgkin lymphoma often mimics benign gallbladder disease, leading to incidental diagnosis on pathology. Surgical resection remains the mainstay of treatment, demonstrably improving survival. Adjuvant chemotherapy or radiotherapy may further enhance outcomes, particularly in advanced presentations. While gallbladder NHL is exceptionally rare, clinicians should maintain a high index of suspicion for this entity within the differential diagnosis.
Key Words
lymphoma; non-Hodgkin lymphoma; gallbladder; low-grade
Case Description
Gallbladder lymphoma is an exceptionally rare malignancy, constituting only about 0.1% to 0.2% of all gallbladder malignancies, which themselves are the fifth most common gastrointestinal malignancy in the United States.1,2 While the vast majority (approximately 98%) of gallbladder cancers are adenocarcinomas, both primary and secondary non-Hodgkin lymphomas (NHL) can involve the gallbladder, with only a handful of cases documented in the literature.2‒6
A 65-year-old man presented with a one-year history of biliary colic without associated symptoms. Labs were unremarkable. Abdominal ultrasound revealed cholelithiasis without acute cholecystitis. He underwent an uncomplicated laparoscopic cholecystectomy for presumed symptomatic cholelithiasis. Omental adhesions suggested chronic cholecystitis, but no other abnormalities were noted.
Pathologic examination confirmed chronic cholecystitis and identified a focal, transmural atypical lymphoid aggregate. Immunohistochemistry revealed the aggregate to be positive for CD20, CD23, BCL-2, and negative for CD3, CD30, BCL-1, and BCL-6. CD21 highlighted a scattered follicular dendritic cell meshwork (Figure 1). The Ki-67 proliferation index was low (5%). Molecular analysis demonstrated clonal B-cell immunoglobulin heavy chain gene rearrangement peaks in the FR2 and FR3 regions, with none detected in the TCR regions. These findings were consistent with a low-grade mature B cell lymphoma with gallbladder involvement.
Figure 1. Gallbladder Pathology. Published with Permission
Bone marrow biopsy, performed as part of staging workup, revealed hypercellular marrow with reduced trilineage hematopoiesis and atypical B-cell infiltrates (Figure 2). Positron emission tomography (PET)/computed tomography (CT) scan identified mesenteric and external iliac lymphadenopathy along with focal bony involvement (Figure 3). The presence of atypical B-cell infiltrates in the bone marrow confirmed stage IV lymphoma by the Lugano classification.7
Figure 2. Bone Marrow Core Biopsy Findings. Published with Permission
The patient received three cycles of bendamustine and rituximab with good tolerability. A post-chemotherapy PET/CT scan demonstrated an adequate response, with a Deauville score of I-II.8 A total of six cycles were planned, delivered in 28-day cycles. However, bendamustine dose reduction was necessary for cycles 4 to 6 due to neutropenia. Eleven months after cholecystectomy, the patient developed a severe SARS-CoV-2 infection, requiring hospitalization, and ultimately succumbed to the complications of COVID-19.
Discussion
Lymphomas are solid tumors of the immune system, predominantly arising from lymph nodes. Non-Hodgkin lymphomas (NHL) are predominantly nodal malignancies, with extranodal involvement occurring in about one-third of cases.9 The gastrointestinal tract is the most common extranodal site, with the stomach being the most frequent location within the GI tract.10 Primary NHL of the biliary tree is exceptionally rare, comprising only 0.4% of extranodal cases and 0.016% of all NHL.11 Secondary gallbladder involvement by systemic lymphoma is equally uncommon.3‒6
In our case, it is questionable whether this patient had a primary or secondary lymphoma of the gallbladder as the patient initially presented at a later disease stage, with widespread lymphadenopathy and concomitant bone marrow involvement at that time. The limited documentation of metastatic lymphoma to the gallbladder further complicates the diagnosis. However, primary involvement cannot be entirely excluded due to the rarity of this presentation. Regardless of the origin, gallbladder involvement by NHL is a rare entity with sparse literature.
Preoperative diagnosis of gallbladder lymphoma remains a significant challenge, particularly for low-grade presentations. Existing literature demonstrates a common pattern: patients initially present with symptoms suggestive of cholelithiasis, and the definitive diagnosis of gallbladder lymphoma is only established incidentally following cholecystectomy.12 Muszynska et al. exemplify this rarity: among 36,355 patients undergoing cholecystectomy for benign reasons, only 3 out of 215 incidentally discovered gallbladder malignancies were lymphomas.4 Our case aligns with this pattern, highlighting the importance of routine pathological examination for all resected specimens, even when some advocate for a more selective approach.13 Definitive diagnosis relies on a combination of histopathological analysis, immunohistochemistry, and potentially molecular studies to confirm the specific lymphoma subtype.
Non-Hodgkin lymphoma of the gallbladder frequently mimics classic gallstone disease. As reported by Tishler et al., a case of large cell NHL was diagnosed only after pathological examination of a gallbladder initially presenting as acute cholecystitis.14 Similarly, in our case, the patient presented with symptoms solely suggestive of cholelithiasis during the initial evaluation and surgical intervention. Notably, only after receiving the pathology report, and upon further questioning, did the patient reveal experiencing weight loss and night sweats. This case emphasizes that, while less frequent, cholecystitis can be secondary to and involve pathologies beyond cholelithiasis.
Although gallbladder lymphoma is typically diagnosed postoperatively, preoperative radiographic evidence may support this rare diagnosis. While Ono et al. suggest that radiographic features may vary depending on lymphoma subtype, with high-grade lymphomas like diffuse large B-cell lymphoma (DLBCL) presenting as bulky masses and low-grade lymphomas showing subtle wall thickening, these findings are not universally observed.2 For instance, Chang et al. reported a case of DLBCL with focal wall thickening on imaging.15 In our case, despite the presence of cholelithiasis, preoperative ultrasound failed to identify features suggestive of lymphoma.
Management of NHL with gallbladder involvement remains poorly defined. Due to the rarity and often postoperative diagnosis, cholecystectomy serves as the mainstay of therapy for primary gallbladder lymphomas. However, for more advanced disease, adjuvant chemotherapy and/or radiation therapy may be necessary.
Ayub et al. reported a higher median survival in surgically treated patients, although their study design might introduce selection bias. Their entire cohort exhibited a median overall survival of 41 months and a 5-year mean survival of 40%. Diffuse large B-cell lymphoma showed the poorest prognosis, with a mean survival of 13 months. These findings suggest that surgical resection significantly improves survival, and the addition of adjuvant radiation therapy might offer further benefit.16
Our patient received adjuvant BR chemotherapy (bendamustine 90 mg/m2 on days 1 and 2, rituximab 375 mg/m2 on day 1) following cholecystectomy, based on his clinical stage for indolent lymphoma. BR is a well-established first-line treatment for follicular lymphoma, marginal zone lymphoma, and mantle cell lymphoma.17,18 The standard dosing regimen involves bendamustine 90 mg/m2 and rituximab 375 mg/m2 on days 1 and 2, repeated in 28-day cycles.17,18 Our patient demonstrated an adequate response to BR, with follow-up imaging indicating improved lymphadenopathy. Unfortunately, a definitive assessment of the patient’s overall survival could not be determined due to his death from complications related to SARS-CoV-2 pneumonia 11 months after diagnosis.
Conclusion
This case report describes a patient with low-grade B-cell gallbladder lymphoma, a malignancy mimicking benign disease and often incidentally diagnosed on pathology. Therefore, we advocate for routine pathological examination of all cholecystectomy specimens. Management is individualized, with surgery being the mainstay for improved survival. Adjuvant chemotherapy or radiotherapy may be indicated for extensive disease or additional survival benefit. While gallbladder involvement by non-Hodgkin lymphoma is an extremely rare event, its inclusion in the differential diagnosis remains crucial for astute clinicians.
Lessons Learned
Gallbladder involvement by non-Hodgkin lymphoma is exceptionally rare. Distinguishing primary extranodal disease from metastasis can be challenging, especially in advanced presentations, as seen in our case. This case highlights that cholecystitis can be a manifestation of less common pathologies beyond cholelithiasis. The disease can mimic acute cholecystitis and often goes undiagnosed until postoperative pathology. As such, advocate for the routine pathological examination of all gallbladders removed during surgery. Incidental findings, particularly those suggestive of malignancy, warrant further investigation. In retrospect, a more thorough preoperative evaluation for B symptoms (fever, night sweats, unexplained weight loss) could have been beneficial. Early identification of such symptoms might have prompted additional workup and imaging, potentially altering the initial management course.
All attempts have been exhausted in trying to contact the patient, next of kin, and/or parent/guardian for informed consent to publish their information, but consent could not be obtained. The editors and reviewers have seen the detailed information available and are satisfied that the information backs up the case the authors are making.
Authors
Nussbaum JEa; Pereira Xb; Tian Xc; Ko Bc; Romero-Velez Gb
Author Affiliations
- Albert Einstein College of Medicine, Bronx, New York
- Department of Surgery. Montefiore Medical Center, Bronx, New York
- Department of Pathology. Montefiore Medical Center, Bronx, New York
- Department of Oncology, Montefiore Medical Center, Bronx, New York
Corresponding Author
Gustavo Romero-Velez, MD
Department of Surgery
Montefiore Medical Center
111 E. 210th Street
Bronx, NY 10467
Email: gustavo.romvel@gmail.com
Disclosure Statement
The authors have no conflicts of interest to disclose.
Funding/Support
The authors have no relevant financial relationships or in-kind support to disclose.
Received: May 11, 2021
Revision received: June 10, 2022
Accepted: July 29, 2022
References
- Rakić M, Patrlj L, Kopljar M, et al. Gallbladder cancer. Hepatobiliary Surg Nutr. 2014;3(5):221-226. doi:10.3978/j.issn.2304-3881.2014.09.03
- Ono A, Tanoue S, Yamada Y, et al. Primary malignant lymphoma of the gallbladder: a case report and literature review. Br J Radiol. 2009;82(973):e15-e19. doi:10.1259/bjr/30768802
- Mani H, Climent F, Colomo L, Pittaluga S, Raffeld M, Jaffe ES. Gall bladder and extrahepatic bile duct lymphomas: clinicopathological observations and biological implications. Am J Surg Pathol. 2010;34(9):1277-1286. doi:10.1097/PAS.0b013e3181e9bb8b
- Muszynska C, Lundgren L, Andersson R, et al. Incidental metastases and lymphoma of the gallbladder - an analysis of ten rare cases identified from a large national database. Scand J Gastroenterol. 2019;54(3):350-358. doi:10.1080/00365521.2019.1588363
- Yun SP, Seo HI. Diffuse large B-cell lymphoma presenting with cholecystitis-like symptoms. Korean J Clin Oncol. 2018;14(1):48-52. doi: 10.14216/kjco.18008
- Rosenberg SA, Diamond HD, Jaslowitz B, Craver LF. Lymphosarcoma: a review of 1269 cases. Medicine (Baltimore). 1961;40:31-84. doi: 10.1097/00005792-196102000-00002
- Cheson BD, Fisher RI, Barrington SF, et al. Recommendations for initial evaluation, staging, and response assessment of Hodgkin and non-Hodgkin lymphoma: the Lugano classification. J Clin Oncol. 2014;32(27):3059-3068. doi:10.1200/JCO.2013.54.8800
- Barrington SF, Qian W, Somer EJ, et al. Concordance between four European centres of PET reporting criteria designed for use in multicentre trials in Hodgkin lymphoma. Eur J Nucl Med Mol Imaging. 2010;37(10):1824-1833. doi:10.1007/s00259-010-1490-5
- Zucca E, Roggero E, Bertoni F, Cavalli F. Primary extranodal non-Hodgkin’s lymphomas. Part 1: Gastrointestinal, cutaneous and genitourinary lymphomas. Ann Oncol. 1997;8(8):727-737. doi:10.1023/a:1008282818705
- Das J, Ray S, Sen S, Chandy M. Extranodal involvement in lymphoma - A Pictorial Essay and Retrospective Analysis of 281 PET/CT studies. Asia Ocean J Nucl Med Biol. 2014;2(1):42-56.
- Gao F, Zhao H, Chen X, Dong X, Liu T, Fu X. Gallbladder non-Hodgkin’s lymphoma: Case report. Int J Surg Case Rep. 2019;61:218-221. doi:10.1016/j.ijscr.2019.07.064
- Psarras K, Symeonidis N, Vlachaki E, et al. Primary gallbladder small lymphocytic lymphoma as a rare postcholecystectomy finding. Case Rep Hematol. 2014;2014:716071. doi:10.1155/2014/716071
- Olthof PB, Metman MJH, de Krijger RR, Scheepers JJ, Roos D, Dekker JWT. Routine Pathology and Postoperative Follow-Up are Not Cost-Effective in Cholecystectomy for Benign Gallbladder Disease. World J Surg. 2018;42(10):3165-3170. doi:10.1007/s00268-018-4619-5
- Tishler M, Rahmani R, Shilo R, Armon S, Abramov AL. Large-cell lymphoma presenting as acute cholecystitis. Acta Haematol. 1987;77(1):51-52. doi:10.1159/000205950
- Chang WY, Chen CC, Wang HP. Unusual endoscopic ultrasonography presentation of gallbladder malignancy: Gallbladder lymphoma. Dig Endosc. 2020;32(3):431. doi:10.1111/den.13573
- Ayub A, Rehmani S, Al-Ayoubi AM, et al. Primary Non-Hodgkin’s Lymphoma of the Gallbladder: A Population-based Analysis. Anticancer Res. 2017;37(5):2581-2586. doi:10.21873/anticanres.11602
- Rummel MJ, Niederle N, Maschmeyer G, et al. Bendamustine plus rituximab versus CHOP plus rituximab as first-line treatment for patients with indolent and mantle-cell lymphomas: an open-label, multicentre, randomised, phase 3 non-inferiority trial [published correction appears in Lancet. 2013 Apr 6;381(9873):1184]. Lancet. 2013;381(9873):1203-1210. doi:10.1016/S0140-6736(12)61763-2
- Flinn IW, van der Jagt R, Kahl BS, et al. Randomized trial of bendamustine-rituximab or R-CHOP/R-CVP in first-line treatment of indolent NHL or MCL: the BRIGHT study. Blood. 2014;123(19):2944-2952. doi:10.1182/blood-2013-11-531327